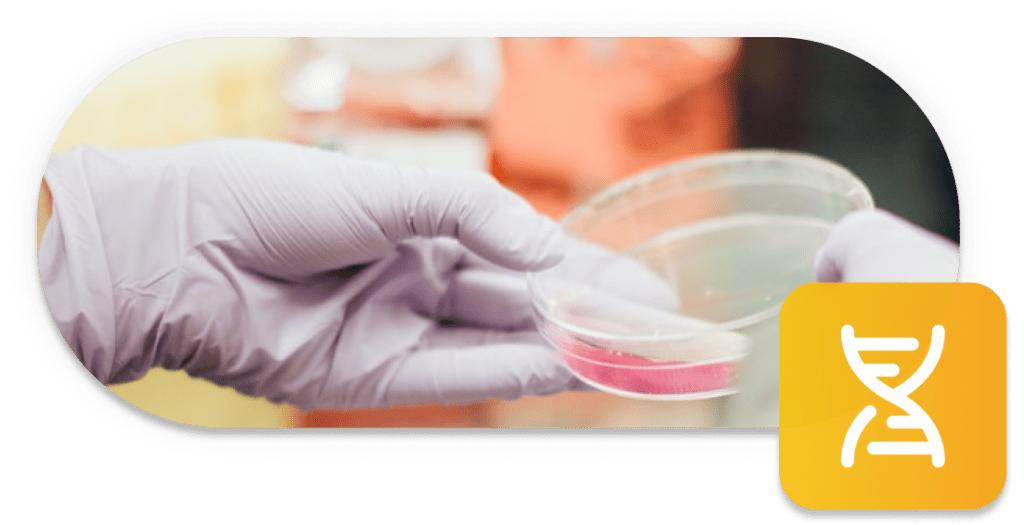

Life Sciences | Pharma | Biotech
In the rapidly advancing sectors of Life Sciences, Pharma, and Biotech, technology drives innovation. Unosquare has the depth of expertise and services to provide solutions that meet your unique needs, from digital engineering outsourcing to digital product development and design.
Experience Across Life Sciences, Pharma, and Biotech
With a proven track record of working with large public organizations across these sectors, we understand the specific challenges and opportunities you face. As our second largest vertical, we have developed playbooks to streamline onboarding and interactions, ensuring a seamless partnership.
Digital Engineering Outsourcing
Ensuring the long-term stability of your team and controlling costs, we keep innovation alive by enhancing and building features and keeping the lights on for every core system in your operation. We operate through our multiple Centers of Excellence, offering various practices, including Product Engineering, QA, Cloud and Infrastructure, and IT Operations.
Digital Product Development
Whether you have an innovative idea and no technology team or your team is stretched thin, we’re here to help develop your MVP to test a market idea. Our onshore high-performance teams and agile methodology ensure efficient product creation. If the MVP shows promise, we transition to our Nearshore team to ensure stable, long-term costs.
Digital Product Design
With a leading position in UX for Life Sciences, Pharma, and Biotech, we specialize in new product design. If you have an idea but need a User Experience team, we can create a prototype for you through a workshop. Our 21-day UX prototype strategy creates your application’s basic views and dummy functionality, which our high-performance teams can further develop.
Tailored for Life Sciences, Pharma, and Biotech
We’ve meticulously developed playbooks to guide our interactions with these sectors. These playbooks encapsulate best practices, strategic insights, and proven methodologies, ensuring we consistently deliver top-quality service. Our approach is flexible, scalable, and designed to evolve with your organization and the industry.
SOC2 Compliant
In an industry where data security is paramount, we understand the importance of compliance. Unosquare is SOC2 compliant, demonstrating our commitment to maintaining the highest data security and protection standards. You can trust us to handle your sensitive information with utmost care and professionalism.
Trusted by Leading Financial Institutions
Our expertise is trusted by leading organizations in Life Sciences, Pharma, and Biotech, including Bayer, Roche, Flatiron Health, Mayo Clinic, and Thermo Fisher Scientific. These organizations rely on us for our ability to deliver technology solutions that drive efficiency, innovation, and growth.
Your Success is Our Success
At Unosquare, your success is our success. Whether you want to optimize your operations, innovate your services, or enhance your patient experiences, we’re ready to support you. We don’t just provide technology solutions; we partner with you to ensure your technology strategy aligns with your business objectives and propels you toward your goals.
Ready to dive in?
Start with Unosquare today.
Unosquare is a full-service, international digital engineering firm. Through our centers of excellence we recruit, train and professionally manage talent to ensure expertise from discovery to delivery.
